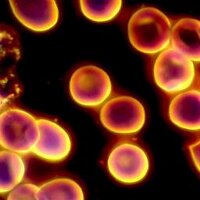
Portobello Biology (@portybiology) 's Twitter Profile Photo Portobello Biology (@portybiology) 's Twitter Profile Photo

Portobello High Sch
@portobellohigh
Secondary School
ID: 4285174755
http://portobellohighschool.org.uk/ 26-11-2015 12:24:28
2,2K Tweet
2,2K Followers
378 Following

Last week we finally got out with some Bronze groups on their qualifier! Top notch campsite carbonara and lovely sunset Portobello High Sch


Thanks to GetMyFirstJob 4Schools - busy 2 days of media workshops and careers panel of Channel 4 professionals Portobello High Sch for S2, S3 and S5. Lots of insights into careers in media!


Thanks so much to Mark Woods with @speakrs4schools for coming along to S5 Media S and Journalism Portobello High Sch to deliver a session about his role as sports journalist - covering how to create engaging content and prepare for an interview. Kickstart the new academic year!



Great day at Royal Highland Show. Fab kids, great staff and the cutest Highland cow calf 🐮 Portobello High Sch





Mr Cuthbertson (music) & Ms Scott (science) felt the pit James Nottingham helped them and their students as a metaphor for learning Portobello High Sch Osiris Educational Mr Cuthbertson said it perfectly applied to learning a musical instrument in his opinion 🙌🏻


Incredible work Portobello High Sch … such creative teaching across this inspirational school. #OTI
A big congratulations to Portobello High Sch S3 today on their fantastic summer fayre!! Such an amazing atmosphere, loads of fun stalls and a very professional car wash. Well done to all involved 🤩


A very emotional final week at Craigmount High School. I had the most amazing year working with so many incredible pupils and staff. I am now moving on to an exciting new venture as a teacher of Drama at Portobello High Sch 🥳




Some new displays showcasing some fantastic SQA results in 2024 and introducing our 27 brilliant S6 language ambassadors for this session 🇫🇷🇪🇸🇮🇹 Portobello High Sch Scottish Association for Language Teaching CEC1+2


Great day at Portobello High Sch - if we don’t connect the workforce of the future with the industries of the future, we won’t get far! Enjoying this work for Powering Futures 🙌

Read about our launch Portobello High Sch with support from Lothian Buses Hitachi Rail (ENG) Social Bite Business Stream Edinburgh Napier University Vattenfall UK and Robertson Construction Group scotsman.com/education/the-…

Absolutely brilliant day Portobello High Sch with our 1st BAME women focused careers event. 13 incredible ladies from a wide range of careers speed networking w/S3-5 girls. V exciting atmosphere & great chat. So lucky to have Blathnaid (DYW) supporting! (Special guests - my sisters)



